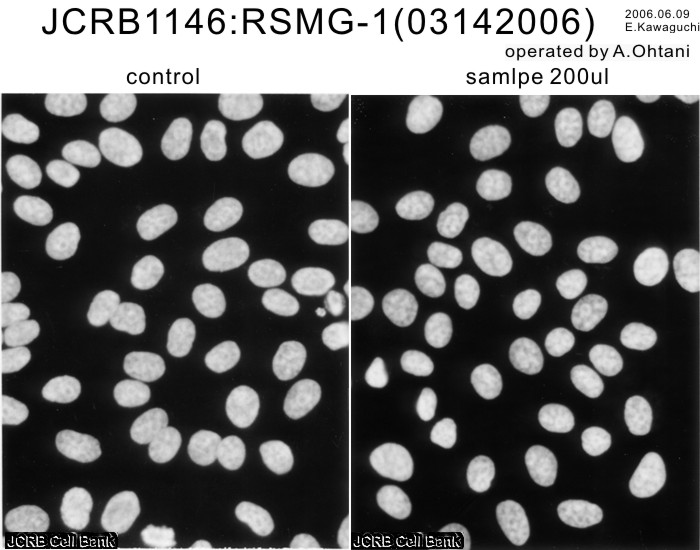

JCRB1146 RSMG-1
Cell information
Important Notice(s)Use and cultivation of RSMG-1 and RSMG-2 cell lines
Cell type:general cells (View Pricing Information)
| JCRB No. | JCRB1146 | Cell Name | RSMG-1 |
|---|---|---|---|
| Profile | Stem cell like cell line from female rat submandibular gland. | Other Name | |
| Animal | rat | Strain | Wistar |
| Genus | Rattus | Species | norvegicus |
| Sex | F | Age | 10-week-old |
| Identity | not done | Tissue for Primary Cancer | submandibular gland |
| Case history | normal | Metastasis | |
| Tissue Metastasized | Genetics | ||
| Life Span | infinite | Crisis PDL | |
| Morphology | epithelial-like | Character | Growth of the RSMG-1 cells are inhibited by activin A, while accelarated by follistatin. The RSMG-1 cells shows a stem cell like characteristics. |
| Classify | normal | Established by | Furue,M. |
| Registered by | Furue,M. | Regulation for Distribution | Must cite the reference, {5541}. |
| Comment | Co-operative research with Dr. Furue,M. recommended because of the special characteristics of the RSMG cells. | Year | 2004 |
| Medium | Serum free MCDB153 medium (Research Inst. for Functional Peptides, Yamagata, Japan) with Supplements (See important notice). | Methods for Passages | Cells are harvested after treatment with 0.05% trypsin in 0.04% EDTA then inactivated by 0.1% soybean trypsin inhibitor. |
| Cell Number on Passage | split ratio = 1/4 | Race | |
| CO2 Conc. | 5 % | Tissue Sampling | selection from whole body culture |
| Tissue Type | submandibular gland epithelial cells |
| Detection of virus genome fragment by Real-time PCR | |||||||||
|---|---|---|---|---|---|---|---|---|---|
| Detected DNA Virus | not tested | Detected RNA Virus | not tested | ||||||
| Reference | |
|---|---|
| Pubmed id:11401526 | Activin A induces expression of rat Sel-1l mRNA, a negative regulator of notch signaling, in rat salivary gland-derived epithelial cells. Furue M,Zhang Y,Okamoto T,Hata RI,Asashima M Biochem Biophys Res Commun. 2001 Apr 6;282(3):745-9 |
| Pubmed id:10937830 | Isoleucine prevents rat salivary gland epithelial cells from apoptosis in serum-free culture. Furue M,Okamoto T,Koshika S,Asashima M In Vitro Cell Dev Biol Anim. 2000 May;36(5):287-9 |
| Pubmed id:10476908 | Effects of hepatocyte growth factor (HGF) and activin A on the morphogenesis of rat submandibular gland-derived epithelial cells in serum-free collagen gel culture. Furue M,Okamoto T,Hayashi H,Sato JD,Asashima M,Saito S In Vitro Cell Dev Biol Anim. 1999 Mar;35(3):131-5 |
| Pubmed id:9719409 | Hepatocyte growth factor regulates activin betaA mRNA in submandibular gland. Furue M,Saito S In Vitro Cell Dev Biol Anim. 1998 Jul-Aug;34(7):520-3 |
| Images |
|---|
![]() ![]() ![]() ![]() ![]() ![]() ![]() ![]() ![]() ![]() ![]() ![]() ![]() ![]() ![]() |
| PDF File1 PDF File2 |
| Movies |
|---|
|
|
LOT Information
Viability/Growth rate/Cell number are represented as actual values measured at lot presentation in JCRB, but are not guaranteed values. Additionally, the doubling time is a rough value measured during passages.| Cell No. | JCRB1146 | Cell Name | RSMG-1 |
|---|---|---|---|
| LOT No. | 03162006 | Lot Specification | distribution |
| Medium | MCDB153+5F+F | Temperature | 37 C |
| Cell Density at Seeding | 1.3x10^4 cells/sq.cm | Methods for Passages | Cells were harvested after treatment with 0.05% trypsin and 0.04% EDTA |
| Doubling Time | NT | Cell Number in Vial (cells/1ml) | 1.2x10^6 |
| Viability at cell freezing (%) | 95.5 | Antibiotics Used | Free |
| Passage Number | P7* | PDL | NT |
| Sterility: MYCOPLASMA | - | Sterility: BACTERIA | - |
| Sterility: FUNGI | - | Isozyme Analysis | G6PD,NP,LDH were examined.Rat confirmed. |
| Chromosome Mode | NT | Chromosome Information | NT |
| Surface Antigen | NT | DNA Profile (STR) | |
| Adhesion | Yes | Exoteric Gene | NT |
| Medium for Freezing | Culture medium containing FAF-BSA and 10% DMSO | CO2 Conc. | 5 % |
| Viability immediately after thawing (%) | Additional information |
| Images |
|---|
![]() ![]() ![]() ![]() ![]() ![]() ![]() |
| Cell No. | JCRB1146 | Cell Name | RSMG-1 |
|---|---|---|---|
| LOT No. | 04222017 | Lot Specification | distribution |
| Medium | MCDB153(Sigma:M7403,including Sodium selenite ) +4F(Insulin,apo-Transferrin ,2-Mercaptoethanol ,Ethanolamine) + FGF-1 with collagen coated dish (See attached file1 and file2) | Temperature | 37 C |
| Cell Density at Seeding | 1-2x10^4 cells/sq.cm | Methods for Passages | Cells were harvested after treatment with 0.05%trypsin(GIBCO) and 0.04% EDTA and scraping.(Split ratio=1/3-1/4) medium change every other day |
| Doubling Time | NT | Cell Number in Vial (cells/1ml) | 3.00x10^6 |
| Viability at cell freezing (%) | 94.4 | Antibiotics Used | |
| Passage Number | P12* | PDL | NT |
| Sterility: MYCOPLASMA | - | Sterility: BACTERIA | - |
| Sterility: FUNGI | - | Isozyme Analysis | NT |
| Chromosome Mode | NT | Chromosome Information | NT |
| Surface Antigen | NT | DNA Profile (STR) | |
| Adhesion | Yes | Exoteric Gene | NT |
| Medium for Freezing | culture medium containing 1mg/ml FAF-BSA with 10% DMSO | CO2 Conc. | 5% |
| Viability immediately after thawing (%) | 88.8 | Additional information | collagen coated dish,medium change every other day, See attached file 1 and file 2,before culture |
| Images |
|---|
|
|